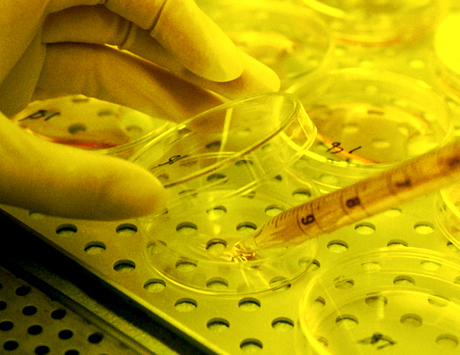
Romiplostym w terapii lenalidomidem u chorych na zespoły mielodysplastyczne – wyniki randomizowanego badania klinicznego II fazy

Romiplostym jest ludzką immunoglobuliną IgG1, białkiem fuzyjnym wiążącym się z receptorem cMp1 w miejscu wiązania trombopoeytyny, aktywującym fosforylację JAK2 i STAT5.
Materiał przeznaczony wyłącznie dla pracowników służby zdrowia
Ten materiał jest dostępny dla zarejestrowanych użytkowników.
Zaloguj się
Szanowni użytkownicy,
część materiałów udostępnianych na naszym portalu jest przeznaczona
wyłącznie dla lekarzy.
Wynika to z regulacji prawnych, do których musimy się stosować.
Jeśli nie jesteś lekarzem, zachęcamy do korzystania z przygotowanych przez nas materiałów dostępnych w zakładce dla pacjentów.